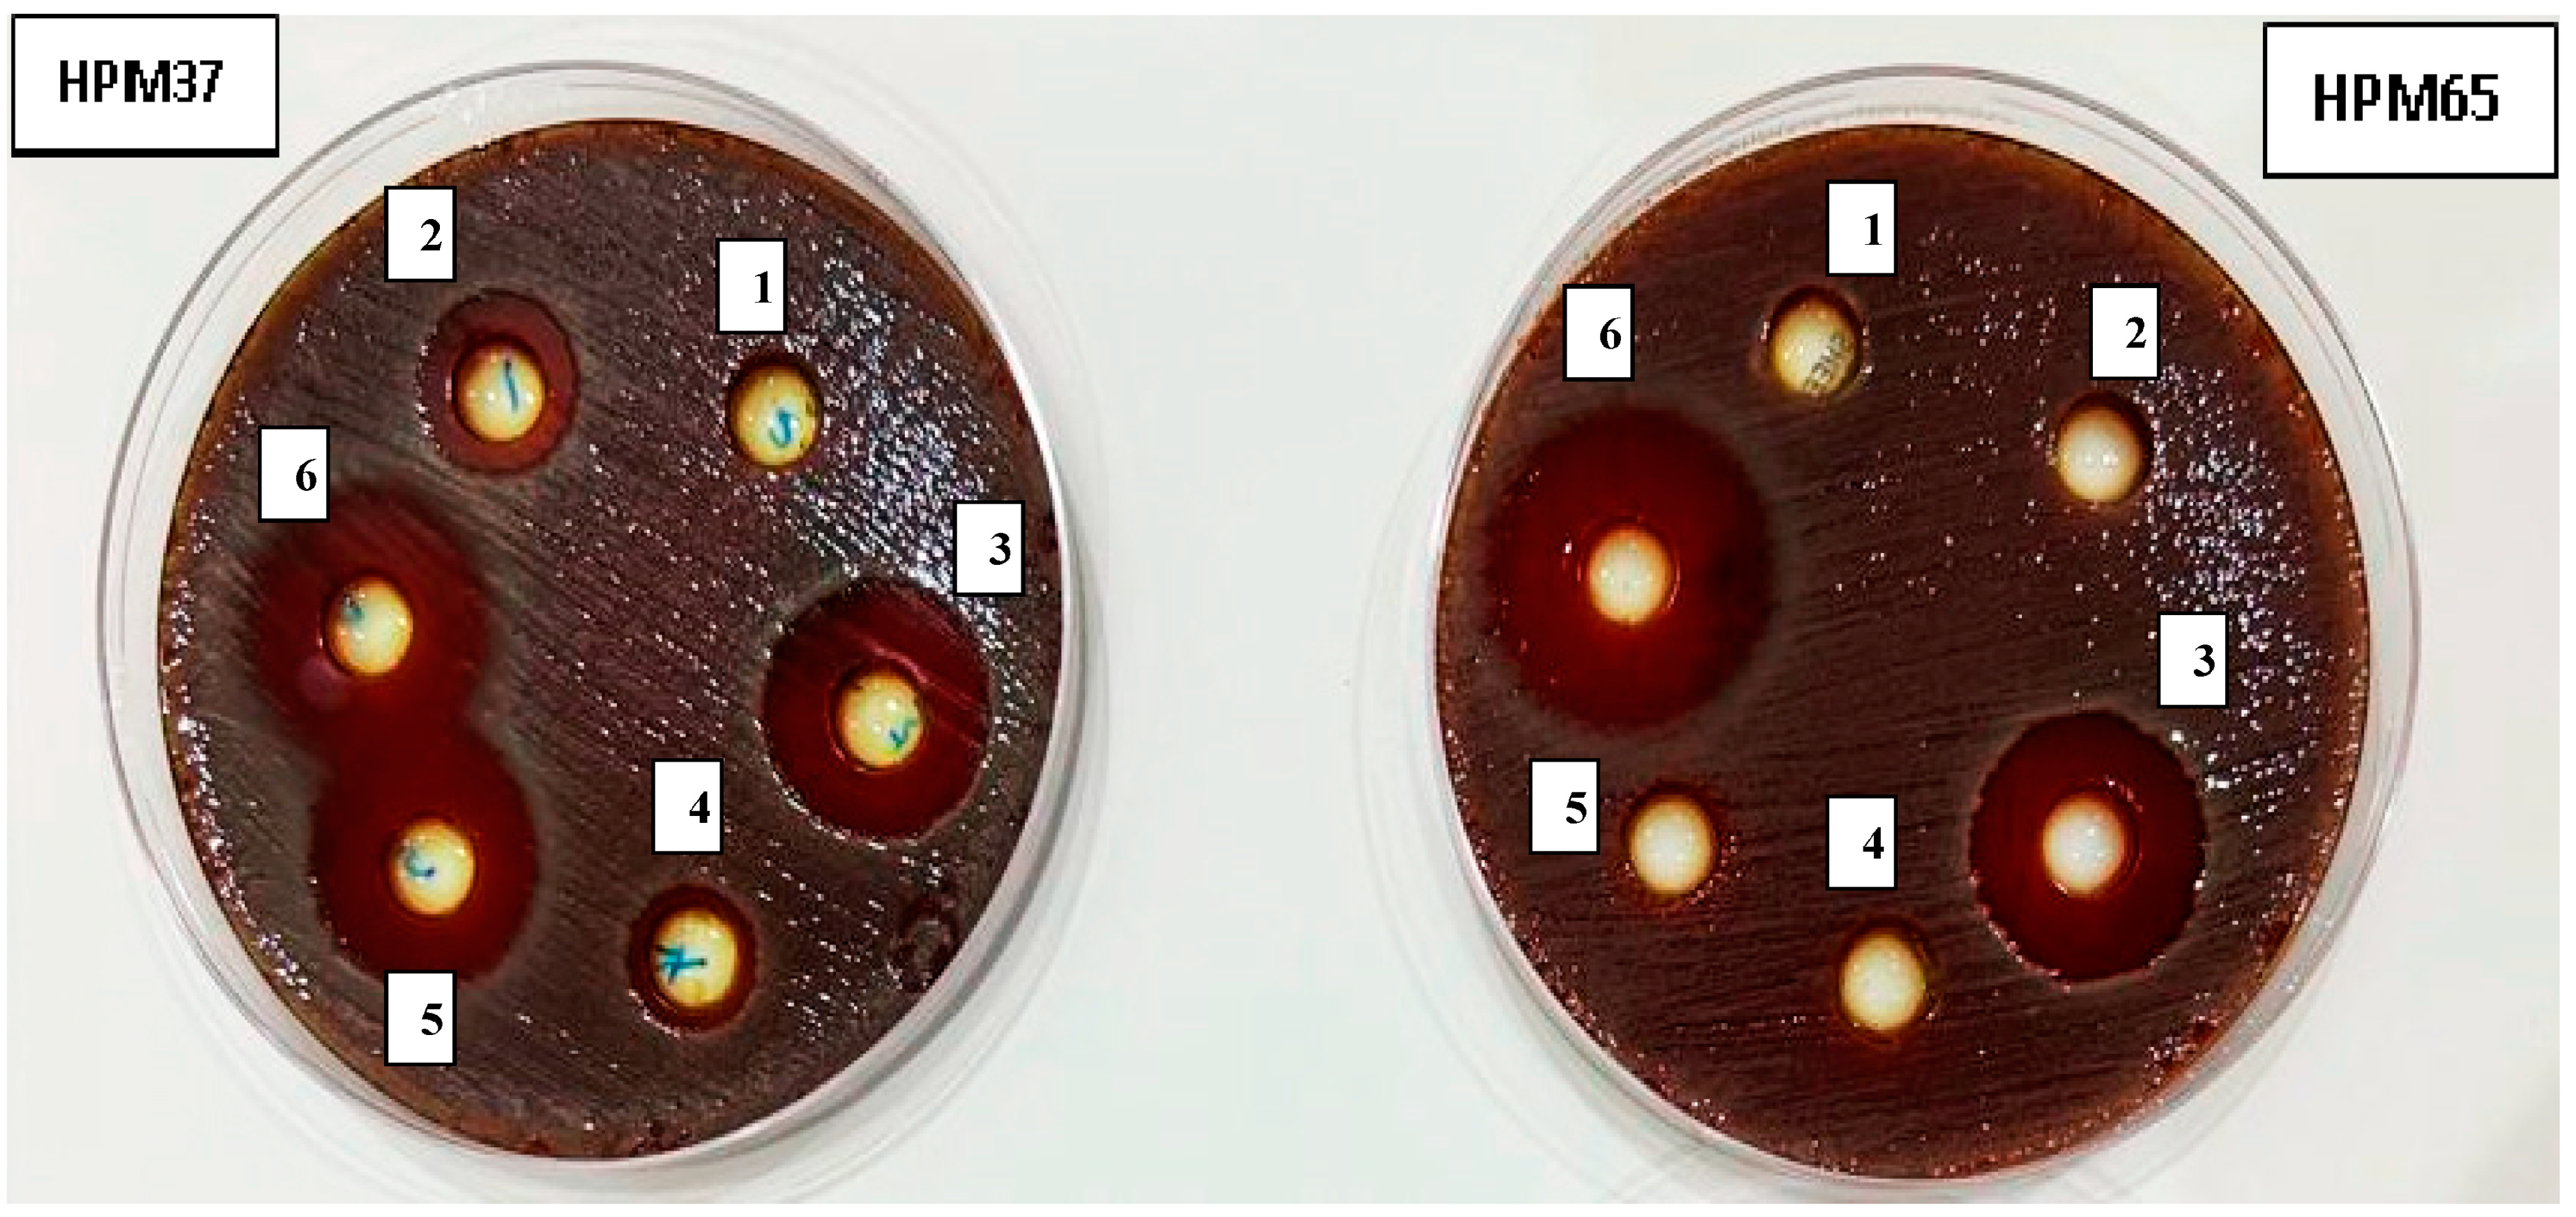
Microbiolres 14 00075 g001

Abstract
The increased emergence of multidrug-resistant Helicobacter pylori is related to many health issues. Zingiber officinale (Z. officinale) is a plant usually used in folk medicine to treat a variety of diseases. This study was conducted to evaluate the ability of Z. officinale extract to combat resistant H. pylori. The disc diffusion, microdilution, and microplate assays were performed to evaluate the susceptibility to antibiotics and the antibacterial and antibiofilm activities of the Z. officinale extracts. Using the checkerboard method, the combined effects of gentamicin and Z. officinale extract were investigated. In addition, anti-inflammatory activity and GC-MS analysis were performed according to a modified protocol. According to the findings, H. pylori isolates exhibited resistance rates of 56.33, 50.0, and 45.85 against metronidazole, gentamicin, and tetracycline, respectively. The methanolic extract of Z. officinale showed the strongest effectiveness against resistant H. pylori isolates with MICs of 20.0 to 50.0 µg/mL, including both H. pylori isolates and the standard strain NCTC 11637. Z. officinale extract suppresses the biofilm formed by H. pylori isolates with a percentage of 92.96% at 50.0 µg/mL, compared with 97.19% for gentamicin at the same concentration. According to FICI values, the combination of methanolic Z. officinale extract with gentamicin increases bacterial sensitivity to such drugs. Moreover, the Z. officinale extract exhibits strong anti-inflammatory activity, with inhibition of red blood cell membrane stabilization increasing from 49.83% to 61.47% at a concentration of 4 to 32 µg/mL. The GC-MS analysis of Z. officinale extract exhibits 17 different chemical compounds. Besides showing antibacterial properties, the extract also contains the anti-inflammatory compound gingerol as the main constituent, which inhibits the growth of H. pylori and its biofilm and is a promising natural therapeutic alternative or enhances antibiotic activity.
1. Introduction
The bacterial resistance to antibiotics has negative effects on the health of millions in both developing and developed nations and has a massive financial influence on society. Amoxicillin and clarithromycin, or amoxicillin and metronidazole, are the two antibiotics used in the H. pylori treatment regimen, together with a proton pump inhibitor. Due to the emergence of drug-resistant strains, standard treatment was unable to completely eradicate H. pylori [1,2]. H. pylori is resistant to antibiotics through different mechanisms. The formation of biofilms modifies the outer membrane proteins associated with antibiotic resistance, and elevating proteinase K levels alters clarithromycin resistance, according to findings by Hathroubi et al. [3]. Moreover, eDNA in biofilms stimulates microbial adhesion, prevents the diffusion of antibiotics, and chelates cations [4]. Some extracellular enzymes in the biofilm deactivate antibiotics [5]. The gastrointestinal tract, particularly the stomach, is colonized by H. pylori [1]. H. pylori is one of the most common causes of human infection, especially in developing countries, where it affects more than 80% of the population [6]. An infection with H. pylori typically persists for the rest of one’s life. This bacterium has also been linked to peptic ulcers, chronic gastritis, and gastric cancer [7,8,9,10]. Despite the fact that the majority of H. pylori infections are asymptomatic, those who are infected are at a significant risk of developing the aforementioned illnesses. H. pylori was categorized as a human carcinogen in category I by the World Health Organization’s International Agency for Research on Cancer in 1994 [11]. Moreover, H. pylori has virulence factors that include flagella, biofilm, outer membrane proteins, catalase, mucinase, lipase, urease, proteases, phospholipase, vacuolating cytotoxin A, cytotoxin-associated gene antigen, and induced contact of the epithelium A, among others, that control the pathogenicity of H. pylori [1,11]. Moreover, several studies have shown that H. pylori strains have the potential to form biofilms in human stomach mucosa both in vitro and in vivo [2,12,13,14,15]. The rapid emergence of multi-drug H. pylori is a strong reason to search for a new approach to eradicating it [16].
In comparison to treatments derived from chemical sources, using plant extracts for the therapeutic treatment of multi-drug-resistant H. pylori has benefits. This approach was preferred because, as compared to those developed from chemical sources, these therapeutics had fewer toxicological and pharmacological side effects. In an attempt to decrease the toxicity of synthetic drugs, researchers in a wide range of disciplines, including gastroenterology and bacteriology, have placed a great deal of emphasis on the pharmacological actions of natural products against H. pylori [12,17]. So, several studies have examined plant compounds that have gastroprotective and anti-H. pylori activity [1,18,19]. Ginger (Zingiber officinale), which belongs to the Zingiberaceae family, has grown in popularity as a complementary medicine in many parts of the world. The methanol extracts of Zingiber officinale prevent the growth of 19 H. pylori strains in vitro with an MIC range of 6.25 to 50 µg/mL. Most H. pylori strains are inhibited by gingerols, an active fraction with an MIC range of 0.78–12.5 µg/mL that has significant activity against CagA positive bacteria [20]. Moreover, Ohno et al. (2003) showed that plant essential oils can inhibit H. pylori isolates from clinical samples and the H. pylori ATCC strain [21]. An infection with H. pylori activates many pro-inflammatory signals. This reaction contributes to the pathophysiology of a number of gastrointestinal illnesses. To treat stomach disease caused by H. pylori infection, the inflammatory response must be under control. Strong anti-inflammatory properties and the ability to stop the release of cytokines that induce inflammation are included in the Zingiber officinale extract [22]. The use of combination therapy has several benefits, including the ability to treat mixed infections and infections caused by a specific causal organism, as well as enhancing antimicrobial activity, reducing the need for continuous antibiotic administration, and stopping the formation of bacteria that are resistant to several drugs [17]. The current work aims to combat multidrug-resistant H. pylori, which causes several health issues, using methanolic Zingiber officinale extract and explore its ability to enhance the antibiotic activity, as well as identify the main bioactive components and the anti-inflammatory activity.
2. Materials and Methods
2.1. Zingiber officinale
Zingiber officinale rhizomes were obtained from the local market in Cairo, Egypt, in 2022. The rhizomes of Z. officinale were washed with distilled water. After drying, the rhizomes of Z. officinale were cut into small parts and ground to powder using an electrical blender (Tornado, 1000 W).
Extraction of Z. officinale (ZO) Preparation
Ten grams of powdered Z. officinale were mixed with 100 mL of methanol (Sigma-Aldrich, St. Louis, MO, USA) to generate the methanol extract, which was then allowed to soak for 24 h at room temperature. Throughout the time spent soaking, the extracts were filtered using Whatman No. 1 filter paper, and the filtrate was then evaporated at 50 °C under decreased pressure in a vacuum evaporator. The extracts were kept in opaque vials and frozen at −10 °C until further research.
2.2. Antibiotic Susceptibility of H. pylori Isolates
Seventy-six previously identified H. pylori isolates and the reference strain NCTC 11637 were grown at 37 °C in Mueller-Hinton broth (MH) medium (Oxoid, UK) supplemented with 5% horse blood until they reached the exponential phase. The turbidity of the bacterial growth was measured using a spectrophotometer set at 620 nm and examined every 30 min to identify the exponential phase. The inoculum density in each bacterial solution was then adjusted to 0.5 McFarland Standard (1.5 × 106 CFU/mL) in sterile saline (0.84% NaCl). Antibiotic susceptibility testing of H. pylori isolates was performed using the disc diffusion technique, as described in the Clinical and Laboratory Standards Institute (CLSI 2020) guidelines (M7-A5) [23]. In brief, 50 µL of the bacterial suspension at the above-mentioned turbidity concentration were inoculated onto (MH) agar medium enriched with 5% horse blood. Antibiotic discs representing different classes of antibiotics (the antibiotics on the panel were ciprofloxacin 5 µg/mL, levofloxacin 5 µg/mL gentamicin 10 µg/mL, neomycin 30 µg/mL, clarithromycin 15 µg/mL, erythromycin 15 µg/mL, tetracycline 30 µg/mL, amoxicillin 25 µg/mL, metronidazole 5 µg/mL, and amoxicillin/clavulanic acid 20/10 µg/mL) were gently loaded on the prepared plates using sterile forceps. Then, they were incubated for 24 h under microaerophilic conditions (10% CO2, 5% O2, and 85% N2) using a gas pack system (Mitsubishi, Japan) at 37 °C. The diameter of the inhibition zone was measured in millimeters (mm), compared with the standard zone diameter given in the protocol chart. It can be determined whether the bacterial isolate is resistant, intermediate, or susceptible to the tested antibiotics.
2.3. Anti H. pylori Activity of (ZO) Extract
Zingiber officinale extract was investigated for its antibacterial activity against resistant H. pylori isolates and H. pylori NCTC 11637. One hundred microliters of bacterial growth (1.5 × 106 CFU/mL) were inoculated into Muller Hinton Blood Agar (MHBA) medium. Paper discs (8 mm) were saturated with 50 µL of crude extract containing 10 mg of (ZO) in DMSO per ml. The saturated paper discs were plated on the surface of the inoculated MHBA plate, and a control antibiotic, gentamicin paper discs containing 25 g/mL, was used on the same plates. The plates were incubated for 48 h at 37 °C under microaerophilic conditions (10% CO2, 5% O2, and 85% N2) using a gas pack system (Mitsubishi, Japan), and the diameter of the inhibitory zone was estimated at (mm). This experiment was performed in three replicates [24].
2.3.1. Determination of Minimum Inhibitory Concentrations (MICs) of (ZO) Extract
The microbroth dilution technique was used to evaluate the MIC of the methanolic extract (ZO) against H. pylori isolates and the standard strain NCTC 11637 using gentamicin (HiMedia Laboratories Pvt. Ltd., Mumbai, Maharashtra, 400086 India) as an antibacterial positive control. In each well of a 96-well microplate, gentamicin and a methanolic extract of (ZO) were coated in twofold serial dilutions. A saline suspension of the test strain was added to each well, and the cultures were incubated at 35 °C for 3 days in a microaerophilic atmosphere (10% CO2, 5% O2, and 85% N2). Z. officinale extract was investigated at concentrations ranging from 0.0, 5.0, 10.0, 15.0, 20.0, 25.0, 30.0, 35.0, 40.0, 45.0, 50.0, 55.0, and 60.0 µg/mL, and gentamicin was started at 0.30, 0.613, 1.25, 2.5, 5.0, 10.0, 20.0, 40.0, and 80.0 g/mL. The experiment was performed according to the criteria of the CLSI 2020 guidelines (M7-A5) [23,25]. Wells containing a negative control (medium + ZO) extract or gentamicin at the tested concentrations) were performed to determine the differences in optical density (OD) at 630 nm. The MIC was defined as the lowest concentration of the Z. officinale extract or gentamycin that can inhibit the visible growth of bacteria.
2.3.2. Checkerboard Assay
Checkerboard is a technique used to determine the synergistic effect between gentamicin and ZO extract. Using the broth microdilution method, two-dimensional checkerboard serial dilutions were carried out, with the concentration of gentamicin decreasing vertically and the concentration of (ZO) decreasing horizontally. The previously prepared stock solution was diluted with Mueller-Hinton broth. Gentamicin concentrations started at 1/128 MIC in the rows, and (ZO) concentrations started at 1/ 128 MIC in the columns. At a density of 106 (CFU)/mL/well, bacterial isolates were inoculated. and the plate was incubated for 24 h at 37 °C. A positive control well included only media with bacteria inoculated and no gentamicin/(ZO) combinations. The negative control wells contained only medium containing the used combinations, with no bacteria inoculated. By comparing the growth of the tested bacteria in the wells with the positive and negative controls, the MIC for the antibacterial agents was identified. A spectrophotometer analyzed the optical density (OD) of the microplate at 620 nm. To determine the correlation between gentamicin and (ZO), the fractional inhibitory concentration index (FICI) was determined with the formula [17].
where, FIC gentamicin = (MIC of gentamicin in the presence of ZO)/(MIC of gentamicin alone) and FICZO = (MIC of ZO in the presence of gentamicin)/(MIC of ZO alone).
FICI = FIC gentamicin + FICZO
Then, the interpretation ranges were applied to the FICI value. (Synergy ≤ 0.5, additive > 0.5 and ≤1.0, Indifference > 1 and ≤4.0, and Antagonism > 4.0)
2.4. Antibiofilm Activity of Methanolic Extract of Z. officinale
The ability of Z. officinale methanolic extract to inhibit biofilm formation by H. pylori isolates at concentrations of 25 and 50 µg/mL and using gentamicin as a control at the same concentrations was assessed using microtiter plate assays. In brief, 0.5 McFarland turbidity was adjusted from 24 h cultures of each isolate to a 100-fold dilution using TBS (Liofilchem, Via Scozia, Zona Industriale 64026, Roseto degli Abruzzi (TE) Italy). Then, 100 µL of this dilution was inoculated in triplicate on a 96-well flat-bottomed polystyrene plate (China) and incubated for 24 h at 37 °C. Each well’s contents were removed, and phosphate-buffered saline (PBS) was used to repeatedly wash the wells. The plate was then air-dried after a 15-min methanol fixation procedure. Each well was stained with 100 µL of 1% crystal violet solution in water and incubated at room temperature for 30 min. Afterward, the stain was solubilized by 100 µL of glacial acetic acid (GAA) (33%), plates were washed with distilled water three times, and then they were dried. The optical density (OD) of each well was read at 570 nm using an enzyme-linked immunosorbent assay (ELISA) reader. Based on the OD average values, the results of the biofilm formation were interpreted as follows: (OD ≤ ODC) = negative (non-biofilm formation); ODC optical density of the control; (ODC ≤ OD ≤ 2 ODC) = weak biofilm formation; (2 ODC ≤ OD ≤ 4 ODC) = moderate biofilm formation; and (4 ODC ≤ OD) = strong biofilm formation [26].
2.5. Anti-Inflammatory Assay by Human RBCs
Using a human red blood cells (HRBCs) technique, the anti-inflammatory activity of Z. officinale extract was examined. An equal volume of Alsever solution (consisting of 0.8% sodium citrate, 2% dextrose, 0.42% sodium chloride, and 0.5% citric acid) was added to the blood of a healthy human volunteer who had abstained from using non-steroidal anti-inflammatory drugs (NSAIDS) for the two weeks before the study began. The mixture was then centrifuged at 3000 rpm. After being isosaline washed from the precipitated cells, a 10% suspension was made. Deionized water was used to prepare different extract concentrations, including 4, 8, 16, and 32 µg/mL. To each concentration, 1 mL of phosphate buffer, 2 mL of hyposaline, and 0.5 mL of HRBC solution were added. After a 30-min incubation period at 37 °C, they conducted a 20-min centrifugation at 3000 rpm. Spectrophotometrically, the supernatant’s hemoglobin concentration at 560 nm was determined [27]. The following equation was used to calculate the inhibition percentage.
2.6. Identification of Chemicals That Constitute Z. officinale Extract by GC-MS
Gas chromatography-mass spectrometry (GC-MS) was used to evaluate, count, and identify the main active components in Z. officinale extract, with a few minor adjustments according to El-Sherbiny et al. [28]. In a nutshell, the Z. officinale extract was dispersed in spectroscopy-grade methanol. The gas chromatography-mass spectrometry was carried out using a Thermo Scientific trace GC1310-ISQ mass spectrometer (Austin, TX, USA) with a direct capillary column (length 30 m, thickness 0.25 µm, internal diameter 25 mm). A 1 µL sample was injected at 250 °C using helium as a carrier gas, divided at a ratio of 1:30. The oven temperature was set at 50 °C for 5 min, then scaled up to 230 °C at a rate of 5 °C/min and let stand for 2 min. At 200 °C and 70 eV, the mass spectrometer was programmed to scan in electron ionization mode from 40 to 1000 m/z. The spectra of known compounds found in the WILEY 09 (Wiley, New York, NY, USA) and NIST 11 libraries were compared with the spectra of the recognized compounds.
2.7. Statistical Analysis
The inhibition zone was calculated as the mean SD value using Minitab 18 software extended with a statistical package and Microsoft Excel.
3. Results and Discussion
3.1. Antibiotics Profile of H. pylori Isolates
The 76 previously identified H. pylori isolates and the reference strain, NCTC 11637, were investigated for their antibiotic susceptibility using disc diffusion techniques. The findings demonstrate that H. pylori isolates are resistant to metronidazole, gentamicin, and tetracycline (56.33%, 50.0%, and 45.85%, respectively). The antibiotics with the highest activity against those isolates were amoxicillin-clavulanate and ciprofloxacin, with sensitivity ratios of 73.36% and 58.95%, respectively. While the standard strain was shown to be susceptible to all antibiotics tested, as shown in Table 1. H. pylori rapidly develops resistance to one treatment and requires combination therapy with different antibiotics. The combination therapy used in the treatment program should be chosen based on the country’s predicted national drug resistance rates [1]. Globally, resistance to metronidazole and clarithromycin has grown over the past several years, lowering the efficacy of conventional first-line treatment regimens and raising the number of treatment failures brought on by drug-resistant H. pylori [29]. A significant number of isolates (73.9%) were previously demonstrated to be resistant to metronidazole, which was followed by amoxicillin (54.3%), clarithromycin (47.8%), ciprofloxacin (13.3%), and tetracycline (4.3%), according to Rasheed et al. [30]. Additionally, a study of antibiotic susceptibility by Tan and colleagues [31] in 2018 on 34 H. pylori strains revealed metronidazole resistance as the most frequent antibiotic resistance (79.4%), followed by clarithromycin (70.6%) and ciprofloxacin (42.9%). Among macrolides, including gentamicin, clarithromycin has been employed in front-line regimens for H. pylori eradication given its two pharmacokinetic features in the stomach: acid stability and amelioration absorption in the gastric mucus layer [32]. By reversibly binding to the peptidyl transferase loop of the 23S ribosomal RNA’s domain V in the bacterial cell, macrolides inhibit protein synthesis and have antibacterial effects. Overall, point mutations in domain V of the 23S rRNA gene are the main cause of clarithromycin resistance in H. pylori [33]. Tetracyclines have been used in a variety of regimens to eradicate H. pylori. The several Tet protein homologs mediate the molecular mechanisms causing H. pylori tetracycline resistance. Despite the fact that H. pylori encodes numerous assumed PBPs and lactamase-like proteins, it causes amoxicillin resistance mainly by decreasing the binding affinity to a specific PBP without generating significant lactamase activity [32]. Fluoroquinolones (moxifloxacin, levofloxacin, and ciprofloxacin) have been used as an alternative first- and second-line H. pylori eradication treatment. These antibiotics have a bactericidal effect by inhibiting two key bacterial type II topoisomerases, topoisomerase IV and DNA gyrase, which modify the chromosomal supercoiling necessary for DNA synthesis, transcription, and cell division [34]. Bacterial resistance to fluoroquinolones is commonly caused by three distinct but non-exclusive mechanisms: target-mediated resistance caused by mutated topoisomerase IV or DNA gyrase; plasmid-mediated resistance caused by plasmids encoding DNA mimics that compete with natural drug targets; enzymes that lower antibiotic activity through acetylation and efflux systems; and chromosome-mediated resistance caused by altered antibiotic uptake and intrinsic efflux systems [32]. In H. pylori, which is naturally absent of these genes, fluoroquinolone resistance is due to target-mediated mechanisms attributed to mutations in single or dual gyrA and gyrB genes encoding Gyr subunits A and B [35].
Table 1.
Antibiotics susceptibility among 76 H. pylori isolates.
3.2. Antibacterial Activity and Minimum Inhibitory Concentration of Z. officinale Extract
To assess the antibacterial activity of Z. officinale extract against H. pylori isolates and the standard strain NCTC 11637, a disc diffusion assay was used. The results showed that Z. officinale extract possesses potential antibacterial activity, with a mean ± SD of inhibition zone ranging from 10 ± 03 to 24 ± 04 mm against both H. pylori isolates and standard strain NCTC 11637, while gentamicin exhibited 20 ± 0.04 against standard strain NCTC 11637, as shown in Table 2 and Figure 1. Several studies reported the antibacterial activity of Z. officinale extract against different bacterial strains isolated from clinical samples and standard strains [36,37,38]. Moreover, many studies [20,22,39] found Z. officinale extract to have antibacterial activity against H. pylori. In this study, the minimum inhibitory concentration of Z. officinale against resistant H. pylori isolates and the standard strain ranged from 20 to 48 µg/mL, while the MIC of gentamicin ranged from 7 to 19 µg/mL, as shown in Table 3. These findings are consistent with those of Mahady et al. [20], who found that a crude methanol extract of Z. officinale suppressed the growth of 14 clinical isolates of H. pylori, four CagA+ strains, and the ATCC-43504 strain, with a MIC of 50.0 µg/mL. Moreover, Azadi et al. [40] found that the ethanolic Z. officinale extract had a MIC of 58 µg/mL against the H. pylori CagA+ strain and that a combination of Z. officinale and cinnamon extract downregulated the CagA gene level by 1.94 times. According to Chakotiya et al. [37], Z. officinale extract changes the permeability and efflux activity of the bacterial cells.
Table 2.
Antibacterial activity of methanolic Z. officinale extract against twenty-five MDR H. pylori isolates and NCTC 11637.
Figure 1.
Antibacterial activity of gentamicin (1), amoxicillin (2), ciprofloxacin (3), Dimethyl sulfoxide (DMSO) (4), amoxicillin-clavulanate r (5), Z. officinale extract (6) against resistant H. pylori isolates (HPM37 and HPM 65).
Table 3.
MIC of Zingiber officinale extract against resistant H. pylori species.
3.3. Synergistic Effect of Gentamicin Combination with Z. officinale Extract against Resistant H. pylori Isolate HPM72
In the checkerboard technique, the interactions between gentamicin and ZO extract against resistant H. pylori isolate HPM72 exhibited thirty-eight treatments causing inhibition of resistant H. pylori isolate HPM72. A synergistic effect was considered when gentamicin and ZO extract combinations showed a FICI value ≤ 0.5; this case was observed with only eleven combinations at different ratios (0.25 + 0.25, 0.25 + 0.125, 0.25 + 0.062, 0.25 + 0.03, 0.125 + 0.25, 0.125 + 0.125, 0.125 + 0.062, 0.062 + 0.25, 0.031 + 0.2, 0.015 + 0.25, and 0.007 + 0.25 (µg/µg)/mL of gentamicin and ZO extract, respectively). Furthermore, there were fourteen combinations with FICI ranging from 1.007 to 1.5, meaning additive effects. On the other hand, one combination showed an indifferent effect when the FICI was 2 (µg/µg)/mL of gentamicin and ZO extract. Through these interactions, the MIC of gentamicin was reduced from 42 µg /mL to 0.125 µg (336-fold), while the MIC of ZO extract was reduced from 33 µg /mL to 0.062 µg (532-fold). The FIC indexes for the tested combinations and their interpretations are presented in Table 4. Combination therapy has many advantages, including treating mixed infections, infections brought on by a particular causative organism, increasing antimicrobial activity, avoiding the need for prolonged antibiotic use, and preventing the emergence of multidrug-resistant bacteria. Combination therapy is the most frequently recommended empirical treatment for bacterial infections in intensive care units [17]. The MIC values against drug-resistant P. aeruginosa and clinical isolates of multidrug-resistant Staphylococcus aureus were dramatically reduced when various antibiotics were combined with crude extracts of several plants [17,41]. Infections brought on by resistant bacterial stains can be treated more effectively when gentamicin and plant extract are combined, according to research conducted by Khameneh et al. [42]. The efflux pumps appeared to be inhibited by secondary plant compounds through competitive and non-competitive inhibition or by lowering the expression of the efflux genes. Due to the concentration and persistence of antibiotics in bacteria, herbal extracts are therefore likely to prevent bacterial resistance to antibiotics. Moreover, Z. officinale extract possesses significant nephroprotective activity, which is induced by gentamicin [43].
Table 4.
Synergistic effect of gentamicin and ZO extract against resistant H. pylori HPM72.
3.4. Antibiofilm Activity of Z. officinale Extract
In this investigation, H. pylori isolates formed biofilm (93.36%) with different degrees, with the moderate degree being the most common. The antibiofilm efficacy of methanolic extracts of Z. officinale in vitro suppressed biofilm formation to various degrees in bacterial isolates at concentrations of 25 and 50 µg/mL compared to gentamicin as the control at the same concentrations Table 5. As shown in Figure 2, the highest reduction of biofilm formation by Z. officinale extract was seen at 50 µg/mL (92.96%). Antibiotic resistance is a result of the structural features of the biofilm and its bacterial constituents. A complex phenomenon, biofilm-related drug resistance, may be greatly influenced by biofilms. Biofilms and related infections can be treated with antibiotics, sanitizers, and germicidal chemicals. When compared to their planktonic stage, bacteria that live in biofilms exhibit a 10–1000-fold increase in drug resistance, particularly antibiotic resistance [44]. According to studies by Hoyle et al., bacteria in dispersed biofilms are 15 times more sensitive to the antibiotic tobramycin than bacteria in intact biofilms [45]. Several studies have revealed the ability of Z. officinale extract to inhibit biofilm formation in different bacterial strains isolated from clinical samples [46,47,48]. According to Kim et al. [48], Z. officinale extract reduces the synthesis of exopolysaccharides in bacterial stains that develop biofilm. H. pylori, which forms biofilms, may play an essential role in antibiotic resistance in clinical settings. Additionally, while the fecal-oral pathway is thought to be the primary mode of transmission for H. pylori, there is evidence that biofilm-forming strains growing on surface-exposed water may provide another route for infection transmission [49]. Moreover, H. pylori can transform into dormant cells known as coccoid forms, for which much higher MICs of different antibiotics are required to achieve bactericidal action [50,51]. Coccoid development may further exacerbate MDR due to an ultrastructural alteration in the cell membrane and metabolic pathways that reduce antibiotic target exposure and antibiotic penetration [52].
Table 5.
Detection of biofilm in 76 H. pylori isolates before and after treatment with Z. officinale and gentamicin.
Figure 2.
Percentage of biofilm suppression with Z. officinale and gentamicin.
3.5. Anti-Inflammatory Activity of Z. officinale Extract
The anti-inflammatory activity of Z. officinale extract was demonstrated in vitro; the inhibition percentage of red blood cell membrane stabilization increased from 49.83% to 61.47% at a concentration of 4 to 32 µg/mL, comparable to 63.72% to 71.43% as an inhibition percentage of the positive control (sodium diclofenac) at the same concentration, as shown in Table 6. Z. officinale has long been used as an anti-inflammatory, and some of its constituents have been shown to have anti-inflammatory properties [53]. Because of the limitations of cyclooxygenase, Z. officinale extract can decrease prostaglandin formation and have the same pharmacological action as non-steroidal anti-inflammatory medications (NSAIDs) [54]. Z. officinale also possesses anti-inflammatory properties that help to reduce gingival bleeding [48]. Moreover, Z. officinale extract decreased the production of IL-1b, IL-6, IL-8, and TNF-a from LPS-stimulated human PBMCs in the fight against H. pylori infection [55].
Table 6.
Assessment of the anti-inflammatory activity of Z. officinale extract.
3.6. Chemical Composition of Z. officinale Extract
Table 7 and Figure 3 indicated that GC-MS screening of Z. officinale methanolic extraction identified approximately 17 distinct chemicals. gingerol (45.05%), zingiberene (16.05%), and thymol (10.50%) were the principal chemicals. Elbashir et al. [56] revealed that gingerol is the primary principal detected component (43%) in the ethanolic extraction of Z. officinale, followed by zingiberene (14%). Z. officinale from the eastern portion of Nigeria had gingerol at peak 12 and ricinoleic acid towards the end [57]. GC-MS screening of the methanol extract of Z. officinale from India detected zingiberene, AR-curcumene, α-bergamotene, gingerol, zingerone, caryophyllene, and ç-elemene [58]. Gingerols extracted from Z. officinale suppress the development of H. pylori Cag A+ strains [20]. Geraniol, another active component in Z. officinale, has numerous pharmacological properties, including antibacterial action against Helicobacter pylori, anti-inflammatory, and anti-ulcer properties [39]. Gingerol inhibits tumor promotion in mouse skin, blocks neoplastic transformation and AP-1 stimulation in mouse epidermal JB6 cells treated with epidermal growth factor, stops human cancer cell proliferation by inducing apoptosis, and prevents pulmonary metastasis in mice implanted with B16F10 melanoma cells [20].
Table 7.
Chemical profile of Zingiber officinale extract by GC-MS.
Figure 3.
GC-MS analysis of Z. officinale methanolic extraction.
4. Conclusions
Based on our findings, the methanolic extract of Z. officinale, which contains gingerol, zingiberene, and thymol as the major compounds, exhibits potential antibacterial and antibiofilm properties against different multidrug-resistant clinical isolates of H. pylori as well as anti-inflammatory activity. The results described herein provide significant enhancement of gentamicin activity against multidrug-resistant H. pylori if it is combined with methanolic Z. officinale extract under the conditions implemented in the current study. Although our findings in this research are encouraging, further studies are required on an animal model to emphasize the anti-H. pylori activity it exhibits in vitro.
Author Contributions
M.K.M.E.: Conceptualization, methodology, and investigation; G.M.E.-S.: Conceptualization, writing—original draft preparation, investigation, supervision; S.A.M.: Conceptualization writing—original draft preparation, supervision, E.E.F.: Conceptualization, writing—original draft preparation, investigation. Writing reviews and editing. All authors have read and agreed to the published version of the manuscript.
Funding
This research received no external funding.
Institutional Review Board Statement
This study was in vitro in nature and did not involve the use of human biological material. Therefore, ethical approval was not required.
Informed Consent Statement
Not applicable.
Data Availability Statement
Not applicable.
Conflicts of Interest
The authors declare no conflict of interest.
References
- El-Sherbiny, G.M.; Mahmoud, K.M. A review—Plant essential oils active against Helicobacter pylori. J. Essent. Oil Res. 2022, 34, 203–215. [Google Scholar] [CrossRef]
- Hou, C.; Yin, F.; Wang, S.; Zhao, A.; Li, Y.; Liu, Y. Helicobacter pylori Biofilm-Related Drug Resistance and New Developments in Its Anti-Biofilm Agents. Infect. Drug Resist. 2022, 15, 1561–1571. [Google Scholar] [CrossRef] [PubMed]
- Hathroubi, S.; Zerebinski, J.; Clarke, A.; Ottemann, K.M. Helicobacter pylori biofilm confers antibiotic tolerance in part via a protein-dependent mechanism. Antibiotics 2020, 9, 355. [Google Scholar] [CrossRef] [PubMed]
- Okshevsky, M.; Meyer, R.L. The role of extracellular DNA in the establishment, maintenance and perpetuation of bacterial biofilms. Crit. Rev. Microbiol. 2015, 41, 341–352. [Google Scholar] [CrossRef] [PubMed]
- Ma, J.F.; Hager, P.W.; Howell, M.L.; Phibbs, P.V.; Hassett, D.J. Cloning and characterization of the Pseudomonas aeruginosa zwf gene encoding glucose-6-phosphate dehydrogenase, an enzyme important in resistance to methyl viologen (paraquat). J. Bacteriol. 1998, 180, 1741–1749. [Google Scholar] [CrossRef] [PubMed]
- Dunn, B.E.; Cohen, H.; Blaser, M.J. Helicobacter pylori. Clin. Microbiol. Rev. 1997, 10, 720–741. [Google Scholar] [CrossRef]
- Blaser, M.J. Helicobacter pylori: Its role in disease. Clin. Infect. Dis. 1992, 15, 386–393. [Google Scholar] [CrossRef]
- Graham, D.Y. Campylobacter pylori and peptic ulcer disease. Gastroenterology 1989, 96 (Suppl. S2), 615–625. [Google Scholar] [CrossRef] [PubMed]
- Parsonnet, J.; Friedman, G.D.; Vandersteen, D.P.; Chang, Y.; Vogelman, J.H.; Orentreich, N.; Sibley, R.K. Helicobacter pylori infection and the risk of gastric carcinoma. N. Engl. J. Med. 1991, 325, 1127–1131. [Google Scholar] [CrossRef]
- Wotherspoon, A.C.; Diss, T.C.; Pan, L.; Isaacson, P.G.; Doglioni, C.; Moschini, A.; De Boni, M. Regression of primary low-grade-B-cell gastric lymphoma of mucosa associated lymphoid tissue type after eradication of Helicobacter pylori. Lancet 1993, 342, 575–577. [Google Scholar] [CrossRef]
- International Agency for Research on Cancer (IARC); World Health Organization. Schistosomes, liver flukes, and Helicobacter pylori. In Monographs on the Evaluation of Carcinogenic Risks; WHO: Geneva, Switzerland, 1994. [Google Scholar]
- Bonifácio, B.V.; dos Santos Ramos, M.A.; Da Silva, P.B.; Bauab, T.M. Antimicrobial activity of natural products against Helicobacter pylori: A review. Ann. Clin. Microbiol. Antimicrob. 2014, 13, 54. [Google Scholar] [CrossRef]
- Stark, R.M.; Gerwig, G.J.; Pitman, R.S.; Potts, L.F.; Williams, N.A.; Greenman, J.; Weinzweig, I.P.; Hirst, T.R.; Millar, M.R. Biofilm formation by Helicobacter pylori. Lett. Appl. Microbiol. 1999, 28, 121–126. [Google Scholar] [CrossRef]
- Cole, S.P.; Harwood, J.; Lee, R.; She, R.; Guiney, D.G. Characterization of monospecies biofilm formation by Helicobacter pylori. J. Bacteriol. 2004, 186, 3124–3132. [Google Scholar] [CrossRef] [PubMed]
- Cellini, L.; Grande, R.; Di Campli, E.; Di Bartolomeo, S.; Di Giulio, M.; Traini, T.; Trubiani, O. Characterization of a Helicobacter pylori environmental strain. J. Appl. Microbiol. 2008, 105, 761–769. [Google Scholar] [CrossRef]
- Hsu, P.I.; Wu, D.C.; Chen, W.C.; Tseng, H.H.; Yu, H.C.; Wang, H.M.; Kao, S.S.; Lai, K.H.; Chen, A.; Tsay, F.W. Randomized controlled trial comparing 7-day triple, 10-day sequential, and 7-day concomitant therapies for Helicobacter pylori infection. Antimicrob. Agents Chemother. 2014, 58, 5936–5942. [Google Scholar] [CrossRef] [PubMed]
- Sharaf, M.H.; El-Sherbiny, G.M.; Moghannem, S.A.; Abdelmonem, M.; Elsehemy, I.A.; Metwaly, A.M.; Kalaba, M.H. New combination approaches to combat methicillin-resistant Staphylococcus aureus (MRSA). Sci. Rep. 2021, 11, 4240. [Google Scholar] [CrossRef]
- Vale, F.F.; Oleastro, M. Overview of the phytomedicine approach against Helicobacter pylori. World J. Gastroenterol. 2014, 20, 5594–5609. [Google Scholar] [CrossRef]
- Wang, Y.C. Medicinal plant activity on Helicobacter pylori-related diseases. World J. Gastroenterol. 2014, 20, 10368–10382. [Google Scholar] [CrossRef]
- Mahady, G.B.; Pendland, S.L.; Yun, G.S.; Lu, Z.; Stoia, A. Ginger (Zingiber officinale Roscoe) and the Gingerols Inhibit the Growth of Cag A+ Strains of Helicobacter pylori. Anticancer Res. 2003, 23, 3699–3702. [Google Scholar] [PubMed]
- Ohno, T.; Kita, M.; Yamaoka, Y.; Imamura, S.; Yamamoto, T.; Mitsufuji, S.; Kodoma, K.; Kashima, T.; Imanishi, J. Antimicrobial activity of essential oils against Helicobacter pylori. Helicobacter 2003, 8, 207–215. [Google Scholar] [CrossRef]
- Song, M.Y.; Lee, D.Y.; Park, S.Y.; Seo, S.A.; Hwang, J.S.; Heo, S.H.; Kim, E.H. Steamed Ginger Extract Exerts Anti-inflammatory Effects in Helicobacter pylori-infected Gastric Epithelial Cells through Inhibition of NF-κB. J. Cancer Prev. 2021, 26, 289–297. [Google Scholar] [CrossRef] [PubMed]
- Clinical and Laboratory Standards Institute (CLSI). 2020 Guidelines (M7-A5); CLSI: Wayne, PA, USA, 2020. [Google Scholar]
- Parekh, J.; Chanda, S. Antibacterial phytochemical studies on twelve species of Indian medicinal plants. Afr. J. Biomed. Res. 2007, 10, 175–181. [Google Scholar] [CrossRef]
- Foda, A.M.; Kalaba, M.H.; El-Sherbiny, G.M.; Moghannem, S.A.; El-Fakharany, E.M. Antibacterial activity of essential oils for combating colistin-resistant bacteria Expert Rev. Anti-Infect. Ther. 2022, 20, 1351–1364. [Google Scholar] [CrossRef] [PubMed]
- Kodori, M.; Nikmanesh, B.; Hakimi, H.; Ghalavand, Z. Antibiotic Susceptibility and Biofilm Formation of Bacterial Isolates Derived from Pediatric Patients with Cystic Fibrosis from Tehran, Iran. Arch. Razi Inst. 2021, 76, 397–406. [Google Scholar]
- Rahman, H.; Eswaraiah, M.C.; Dutta, A. In-vitro anti-inflammatory and anti-arthritic activity of Oryza sativa Var. joha rice (an aromatic indigenous rice of Assam). Am. Eurasian J. Agric Environ. Sci. 2015, 15, 115–121. [Google Scholar]
- El-Sherbiny, G.M.; Gazelly, A.M.; Sharaf, M.H.; Moghannemm, S.A.; Shehata, M.; Ismail, M.K.A.; El-Hawary, A.S. Exploitation of the antibacterial, antibiofilm and antioxidant activities of Salvadora persica (Miswak) extract. J. Bioresour. Bioprod. 2022, 8, 59–65. [Google Scholar] [CrossRef]
- Thung, I.; Aramin, H.; Vavinskaya, V.; Gupta, S.; Park, J.Y.; Crowe, S.E.; Valasek, M.A. Review article: The global emergence of Helicobacter pylori antibiotic resistance. Aliment. Pharmacol. Ther. 2016, 43, 514–533. [Google Scholar] [CrossRef]
- Rasheed, F.; Campbel, B.J.; Alfizah, H.; Varro, A.; Zahra, R.; Yamaoka, Y.; Mark, D. Pritchard Analysis of Clinical Isolates of Helicobacter pylori in Pakistan Reveals High Degrees of Pathogenicity and High Frequencies of Antibiotic Resistance. Helicobacter 2014, 19, 387–399. [Google Scholar] [CrossRef]
- Tan, B.; Yang, J.C.; Young, C.L.; Bishu, S.; Owyang, S.Y.; El-Zaatari, M.; Zhang, M.; Grasberger, H.; Qian, J.M.; Kao, J.Y. Helicobacter pylori Antimicrobial Susceptibility Testing-Guided Salvage Therapy in the USA: A Real Life Experience. Dig. Dis. Sci. 2018, 63, 437–445. [Google Scholar] [CrossRef]
- Tshibangu-Kabamba, E.; Yamaoka, Y. Helicobacter pylori infection and antibiotic resistance—From biology to clinical implications. Nat. Rev. Gastroenterol. Hepatol. 2021, 18, 613–629. [Google Scholar] [CrossRef]
- Gaynor, M.; Mankin, A.S. Macrolide antibiotics: Binding site, mechanism of action, resistance. Curr. Top. Med. Chem. 2003, 3, 949–960. [Google Scholar] [CrossRef]
- Correia, S.; Poeta, P.; Hébraud, M.; Capelo, J.L.; Igrejas, G. Mechanisms of quinolone action and resistance: Where do we stand? J. Med. Microbiol. 2017, 66, 551–559. [Google Scholar] [CrossRef]
- Mori, H.; Suzuki, H.; Matsuzaki, J.; Masaoka, T.; Kanai, T. Acquisition of double mutation in gyrA caused high resistance to sitafloxacin in Helicobacter pylori after unsuccessful eradication with sitafloxacin-containing regimens. United Eur. Gastroenterol. J. 2018, 6, 391–397. [Google Scholar] [CrossRef]
- EL-Sherbiny, G.M. Antimicrobial Susceptibility of Bacteria Detected from the Root Canal Infection (Before and After) Root-Filled Teeth: An in Vitro Study. Int. J. Dent. Sci. Res. 2015, 3, 4–9. [Google Scholar] [CrossRef]
- Chakotiya, A.S.; Tanwar, A.; Narula, A.; Sharma, R.K. Zingiber officinale: Its antibacterial activity on Pseudomonas aeruginosa and mode of action evaluated by flow cytometry. Microb. Pathog. 2017, 107, 254–260. [Google Scholar] [CrossRef] [PubMed]
- Jing, Y.; Cheng, W.; Ma, Y.; Zhang, Y.; Li, M.; Zheng, Y.; Zhang, D.; Wu, L. Structural Characterization, Antioxidant and Antibacterial Activities of a Novel Polysaccharide from Zingiber officinale and Its Application in Synthesis of Silver Nanoparticles. Front. Nutr. 2022, 9, 917094. [Google Scholar] [CrossRef]
- Bhattamisra, S.K.; Yean, V.L.; Lee, C.K.; Kuean, C.H.; Candasamy, M.; Liew, Y.K.; Sahu, P.S. Protective activity of geraniol against acetic acid and Helicobacter pylori-induced gastric ulcers in rats. J. Tradit. Complement. Med. 2019, 9, e206–e214. [Google Scholar] [CrossRef]
- Azadi, M.; Ebrahimi, A.; Khaledi, A.; Esmaeili, D. Study of inhibitory effects of the mixture of cinnamon and ginger extracts on cagA gene expression of Helicobacter pylori by Real-Time RT-PCR technique. Gene Rep. 2019, 17, 100493. [Google Scholar] [CrossRef]
- Fatemi, N.; Sharifmoghadam, M.R.; Bahreini, M.; Khameneh, B.; Shadifar, H. Antibacterial and Synergistic Effects of Herbal Extracts in Combination with Amikacin and Imipenem Against Multidrug-Resistant Isolates of Acinetobacter. Curr. Microbiol. 2020, 77, 1959–1967. [Google Scholar] [CrossRef]
- Khameneh, B.; Iranshahy, M.; Ghandadi, M.; Ghoochi Atashbeyk, D.; Fazly Bazzaz, B.S.; Iranshahi, M. Investigation of the antibacterial activity and efflux pump inhibitory effect of co-loaded piperine and gentamicin nanoliposomes in methicillin-resistant Staphylococcus aureus. Drug Dev. Ind. Pharm. 2015, 41, 989–994. [Google Scholar] [CrossRef]
- Lakshmi, B.V.S.; Sudhakar, M. Protective Effect of Zingiber officinale on Gentamicin-Induced Nephrotoxicity in Rats. Int. J. Pharmacol. 2010, 6, 58–62. [Google Scholar]
- Sharma, S.; Mohler, J.; Mahajan, S.D.; Schwartz, S.A.; Bruggemann, L.; Aalinkeel, R. Microbial Biofilm: A Review on Formation, Infection, Antibiotic Resistance, Control Measures, and Innovative Treatment. Microorganisms 2023, 11, 1614. [Google Scholar] [CrossRef] [PubMed]
- Hoyle, B.D.; Wong, C.K.; Costerton, J.W. Disparate efficacy of tobramycin on Ca2+-, Mg2+-, and HEPES-treated Pseudomonas aeruginosa biofilms. Can. J. Microbiol. 1992, 38, 1214–1218. [Google Scholar] [CrossRef] [PubMed]
- Aghazadeh, M.; Bialvaei, A.Z.; Aghazadeh, M.; Kabiri, F.; Saliani, N.; Yousefi, M.; Eslami, H.; Kafil, H.S. Survey of the Antibiofilm and Antimicrobial Effects of Zingiber officinale (in Vitro Study). Jundishapur. J. Microbiol. 2016, 9, e30167. [Google Scholar] [CrossRef]
- Faria, T.R.B.; Furletti-Goes, V.F.; Franzini, C.M.; de Aro, A.A.; de Andrade, T.A.M.; Sartoratto, A.; de Menezes, C.C. Anti-inflammatory and antimicrobial effects of Zingiber officinale mouthwash on patients with fixed orthodontic appliances. Am. J. Orthod. Dentofac. Orthop. 2021, 159, 21–29. [Google Scholar] [CrossRef]
- Kim, H.-S.; Park, H.-D. Ginger Extract Inhibits Biofilm Formation by Pseudomonas aeruginosa PA14. PLoS ONE 2013, 8, e76106. [Google Scholar] [CrossRef]
- Mackay, W.; Gribbon, L.; Barer, M.; Reid, D. Biofilms in drinking water systems: A possible reservoir for Helicobacter pylori. J. Appl. Microbiol. 1998, 85, 52S–59S. [Google Scholar]
- Sarem, M.; Corti, R. Role of Helicobacter pylori coccoid forms in infection and recrudescence. Gastroenterol. Hepatol. 2016, 39, 28–35. [Google Scholar] [CrossRef]
- Elbestawy, M.K.M.; El-Sherbiny, G.M.; Moghannem, S.A. Antibacterial, Antibiofilm and Anti-Inflammatory Activities of Eugenol Clove Essential Oil against Resistant Helicobacter pylori. Molecules 2023, 28, 2448. [Google Scholar] [CrossRef]
- Kadkhodaei, S.; Siavoshi, F.; Akbari Noghabi, K. Mucoid and coccoid Helicobacter pylori with fast growth and antibiotic resistance. Helicobacter 2020, 25, e12678. [Google Scholar]
- Ali, B.H.; Blunden, G.; Tanira, M.O.; Nemmar, A. Some phytochemical, pharmacological and toxicological properties of ginger (Zingiber officinale Roscoe): A review of recent research. Food Chem. Toxicol. 2008, 46, 409–420. [Google Scholar] [CrossRef]
- Charlier, C.; Michaux, C. Dual inhibition of cyclooxygenase-2 (COX-2) and 5-lipoxygenase (5-LOX) as a new strategy to provide safer non-steroidal anti-inflammatory drugs. Eur. J. Med. Chem. 2003, 38, 645–659. [Google Scholar] [CrossRef]
- Grzanna, R.; Lindmark, L.; Frondoza, C.G. Ginger—An herbal medicinal product with broad anti-inflammatory actions. J. Med. Food 2005, 8, 125–132. [Google Scholar] [CrossRef] [PubMed]
- Elbashir, D.M.M.; Kehail, M.A.A.; Mohamed, A.I.A.; Ali, A.E.H. Phytochemistry and GC-MS Screening and Biocidal Potentiality of Ginger (Zingiber officinale) Rhizome against Mosquito’s Larvae. Int. J. Sci. Res. Arch. 2021, 3, 90–96. [Google Scholar] [CrossRef]
- Chinonye, I.I.; Oze, R.N.; Lynda, O.U.; Nkwoada, A.; Adanma, A.U. Phytochemical and GC/MS Analysis of the Rhizome of Zingiber officinale Plant Grown in Eastern Part of Nigeria. Afr. J. Biol. Med. Res. 2018, 1, 43–54. [Google Scholar]
- Choudhari, S.S.; Kareppa, B.M. Identification of Bioactive Compounds of Z. Officinale Roscoe Rhizomes through Gas Chromatography and Mass Spectrometry. Intern. J. Pharmac. Res. Dev. 2013, 5, 16–20. [Google Scholar]
Disclaimer/Publisher’s Note: The statements, opinions and data contained in all publications are solely those of the individual author(s) and contributor(s) and not of MDPI and/or the editor(s). MDPI and/or the editor(s) disclaim responsibility for any injury to people or property resulting from any ideas, methods, instructions or products referred to in the content. |
© 2023 by the authors. Licensee MDPI, Basel, Switzerland. This article is an open access article distributed under the terms and conditions of the Creative Commons Attribution (CC BY) license (https://creativecommons.org/licenses/by/4.0/).